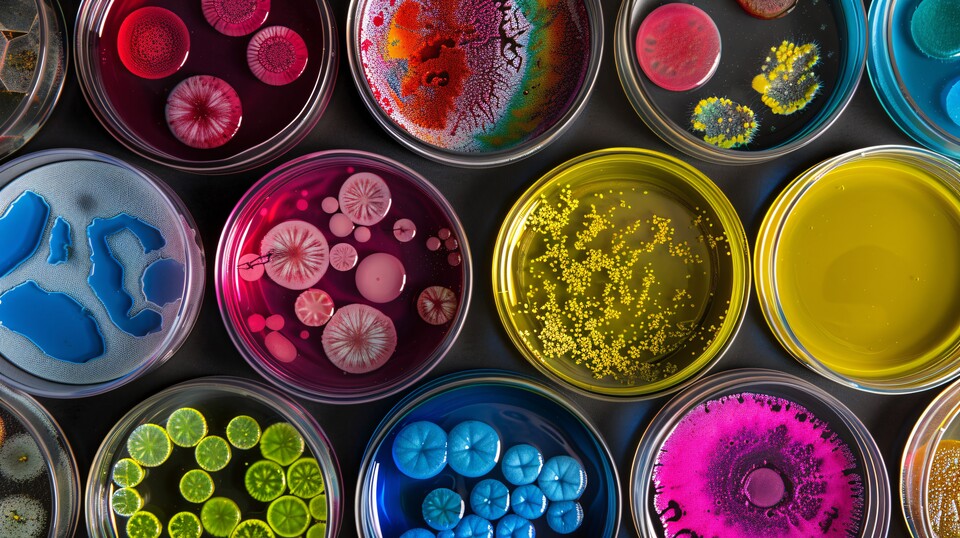
Auf Computer-Tastaturen lässt sich allerhand Unappetitliches finden. (Quelle: IgnacioJulian, Adobe Stock)

So langsam neigt sich die Infektionszeit dem Ende zu. Grund zur Entwarnung ist das allerdings nicht, denn ihr habt alle täglich intensiven Kontakt zu einer potenziellen Infektionsquelle: euer Computer-Tastatur!
Hand aufs Herz, ihr esst doch auch gerne beim Zocken oder neben der Arbeit mal schnell was am Computer, oder? Da bleibt es natürlich nicht aus, dass Krümel und andere kleine Essensreste früher oder später in die Tastatur gelangen und dort fröhlich vor sich hin gammeln.
Hinzu kommt, dass ihr beim Rundgang durch die Wohnung oder euren Arbeitsplatz häufig irgendwelche Dinge wie Türklinken, Griffe von Schränken oder Stifte anfasst und vielleicht auch dem ein oder anderen Kollegen mal die Hand schüttelt.
Regelmäßiges Händewaschen ist Pflicht
Auf diese Weise tragt ihr Keime und Bakterien direkt zu eurer Tastatur, auf der sie sich ausbreiten können. Noch schlimmer wird es, wenn mehrere Menschen gemeinsam eine Tastatur benutzen. Dann steigt die Kontamination mit der Zahl der Nutzer exponentiell an.
Hättet ihr gedacht, dass laut einer Studie der SRH Hochschule Heidelberg rund 11 Prozent der Männer und 3 Prozent der Frauen nach einem Toilettengang auf das Händewaschen verzichtet? Ganze 27 Prozent verwenden nur Wasser und keine Seife. Das ist ziemlich eklig und es wird noch viel ekliger, wenn eine solche Person eure Eingabegeräte am PC verwendet.
Mehr Keime und Bakterien als auf einem Toilettensitz
Wirklich krass ist dazu eine Studie der University of Arizona: Dort hat man herausgefunden, dass sich auf einem durchschnittlichen Schreibtisch 400-mal mehr Bakterien tummeln als auf einem durchschnittlichen Toilettensitz.
Zwar bezieht sich die genannte Studie auf Computer, die im Gesundheitsbereich eingesetzt werden, in etwas abgeschwächter Form dürfte sich an dem Ergebnis aber auch im normalen Büroumfeld wenig ändern. Leider ist die Studie online nicht zugänglich, dafür allerdings eine Studie der University of Seatle, die zu ähnlichen Ergebnissen kommt.
Man mag eigentlich nicht darüber nachdenken, was man so alles an Keimen und Bakterien aufnimmt, wenn man jetzt noch am Computer sein Frühstück einnimmt.
Die Zahl der Bakterien steigt mit der Zahl der Nutzer
Dass eine Tastatur, die mehrere Menschen gemeinsam verwenden, noch einmal deutlich mehr Bakterien aufweisen kann als ein Keyboard, das nur von einer Person genutzt wird, ist die logische Konsequenz. Das wurde unter anderem in einer Studie der australischen University of Technology Swinburne bestätigt.
Tastaturen können ein potenzielles gesundheitliches Risiko sein. Hier könnt ihr euch nicht nur zuverlässig die nächste Erkältung einfangen, sondern euch unter Umständen auch mit dem Corona-, Grippe- oder dem Norovirus infizieren. Selbst Antibiotika-resistente Keime wurden schon auf Keyboards gefunden.
Folgende Bakterien wurden in der Studie unter anderem gefunden:
- Staphylococcus aureus: Kann bei Menschen mit geschwächtem Immunsystem Wundinfektionen bis hin zur Sepsis hervorrufen.
- Enterobacteriaceae: Dabei handelt es sich um Bakterien aus dem Verdauungstrakt. Sie können neben Durchfall auch Harnwegsinfektionen auslösen.
- Enterococcus faecalis: Das Bakterium ist verwandt mit den Streptokokken und kann Harnwegsinfektionen oder eine Sepsis auslösen.
- Bacillus cereus: Ist für einen großen Teil aller Lebensmittelvergiftungen verantwortlich und löst starkes Erbrechen und Durchfall aus.
Natürlich enthält nicht jede Tastatur alle diese Bakterien, je mehr Menschen sie allerdings benutzen, desto größer ist aber auch die Wahrscheinlichkeit einer entsprechenden Kontamination. Noch relevanter dürfte allerdings die Gefahr einer Schmierinfektion sein.
Viren wie Noro oder Influenza können so übertragen werden. Es kann bereits ausreichen, wenn sich ein erkrankter Kollege die Nase putzt und danach nicht die Hände wäscht. Wenn man nun noch berücksichtigt, wie viele sich nach dem Toilettengang nicht die Hände waschen, verwundert es auch nicht, warum im Herbst und Winter der Norovirus immer mal wieder die Runde macht.
Ein feuchtes Tuch alleine reicht nicht aus
Natürlich seid ihr den Viren und Bakterien nicht hilflos ausgeliefert. Ihr könnt leicht etwas dagegen tun, aber ihr müsst es richtig machen. Einfach nur die Tastatur mit einem feuchten Tuch abreiben bringt in der Regel nichts.
Für eine gründliche Reinigung empfehle ich euch das folgende Vorgehen:
- Trennt zur Sicherheit die Tastatur vom Computer, bei Laptops den Rechner herunterfahren.
- Dreht die Tastatur auf den Kopf und klopft auf die Unterseite, um den gröbsten Schmutz loszuwerden. Ein ausgeschaltetes Notebook könnt ihr auch auf den Kopf drehen und nicht zu fest auf die Unterseite des Gehäuses klopfen.
- Befeuchtet ein weiches und fusselfreies Tuch mit Desinfektionsmittel oder Isopropylalkohol und reibt die Tasten sorgfältig ab. Es reicht, wenn das Tuch feucht ist, es sollte nicht triefend nass sein.
- Reinigt auch hin und wieder die Zwischenräume der einzelnen Tasten mit einem mit Desinfektionsmittel oder Alkohol getränkten Wattestäbchen.
Tastatur im Büro am besten täglich desinfizieren
Mit Desinfektionsmittel abreiben solltet ihr eure private und nur von euch genutzte Tastatur am besten einmal pro Woche, wenn ihr denn regelmäßig eure Hände wascht. Wenn ihr Eingabegeräte verwendet, welche mehrere Personen nutzen, empfiehlt sich eine tägliche Reinigung.
Ich selbst habe mir angewöhnt, jede Tastatur, die ich mit anderen Personen teile, bei jeder Verwendung kurz abzureiben. Dazu habe ich mir einen kleinen Spender mit Desinfektionstüchern zugelegt. Das kostet keine 12 Euro und erhöht bei regelmäßiger Anwendung die Hygiene deutlich.
Übrigens, nicht nur Tastaturen sind ein Hort für Bakterien, Keime und Viren, das Gleiche gilt auch für Smartphones, normale Telefone und Computermäuse. Also auch hier gilt: regelmäßiges Desinfizieren kann eure Gesundheit schützen.





![Ein Vater spielte mit seinem Kind jahrelang auf der PS2, weil er sich nichts Besseres leisten konnte. Jahre später schenkte ihm der inzwischen erwachsene Sohn eine PS4 Pro [Best of GameStar]](http://images.cgames.de/images/gamestar/256/reddit-geschenkte-ps4-pro-teaser-redditcom-piyush3000_6308315.jpg)




Nur angemeldete Benutzer können kommentieren und bewerten.
Dein Kommentar wurde nicht gespeichert. Dies kann folgende Ursachen haben:
1. Der Kommentar ist länger als 4000 Zeichen.
2. Du hast versucht, einen Kommentar innerhalb der 10-Sekunden-Schreibsperre zu senden.
3. Dein Kommentar wurde als Spam identifiziert. Bitte beachte unsere Richtlinien zum Erstellen von Kommentaren.
4. Du verfügst nicht über die nötigen Schreibrechte bzw. wurdest gebannt.
Bei Fragen oder Problemen nutze bitte das Kontakt-Formular.
Nur angemeldete Benutzer können kommentieren und bewerten.
Nur angemeldete Plus-Mitglieder können Plus-Inhalte kommentieren und bewerten.